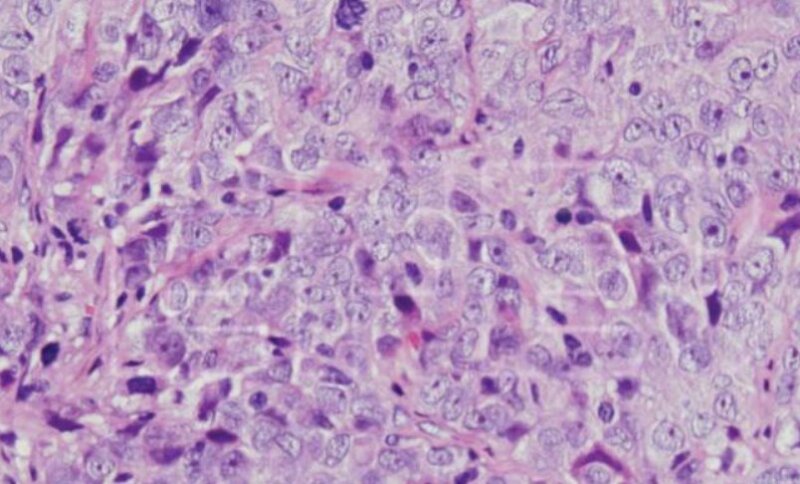
Hallan una vía molecular implicada en el cáncer de ovario y en su resistencia

Esta investigación de la vía molecular ayudará a conocer mejor la fisiopatología de los tumores del cáncer de ovario y a mejorar las terapias
Un equipo de científicos ha identificado una vía molecular implicada en el cáncer de ovario y en la generación de resistencias a los tratamientos. Un avance que ayudará a conocer mejor la fisiopatología de estos tumores y a mejorar las terapias.
El estudio, liderado por Azucena Esparís-Ogando, del Centro de Investigación del Cáncer (Universidad de Salamanca-CSIC) y del CIBER de Cáncer, se ha hecho en colaboración con el Hospital Clínico San Carlos-Madrid, el Hospital Universitario de Salamanca y la Universidad de Dakota del Sur, en Estados Unidos.
El cáncer de ovario es uno de los cánceres ginecológicos más mortales en las mujeres. Cada año se diagnostican unos 300.000 nuevos casos en todo el mundo y se producen unas 200.000 muertes.
La mayoría de estos cánceres son de origen epitelial. Se suelen diagnosticar en un estadio avanzado porque no presentan síntomas ni signos específicos en su fase inicial.
Estas circunstancias le confieren un mal pronóstico y exigen el desarrollo de nuevas estrategias terapéuticas para combatir la evolución de la enfermedad.
En este contexto, el estudio se ha centrado en la búsqueda de nuevas entidades moleculares implicadas en la progresión de los tumores epiteliales de ovario. Y ha evaluado la eficacia clínica de posibles terapias dirigidas a dichas moléculas.
El equipo analizó en diferentes líneas celulares de cáncer de ovario epitelial el estado de activación de unas cuarenta proteínas que participan en varias rutas de señalización. Identificó una proteína, denominada WNK1, que se encontraba anormalmente activa en las líneas celulares analizadas.
Afección de la proteína WNK1
Tras estudiar el estado de activación de esta proteína en tumores de pacientes diagnosticadas con diferentes tipos de cáncer de ovario, el equipo comprobó que WNK1 afectaba drásticamente a la supervivencia de las pacientes.
El equipo también descubrió que esta proteína controla la proliferación celular y la progresión tumoral a través de la vía de señalización MEK5/ERK5. Un hallazgo que abre la posibilidad de actuar sobre esta vía con fines terapéuticos.
Otro hallazgo destacado de la investigación se refiere a la resistencia a los tratamientos.
El estudio ha constatado que cuando se tratan las células de cáncer de ovario con Trametinib, la célula tumoral se defiende activando el eje de señalización de las proteínas WNK1-MEK5-ERK5, lo que disminuye la eficacia antitumoral del fármaco.
El equipo sugiere que la eficacia del tratamiento combinado de Trametinib con inhibidores de la vía de ERK5 es mejor que el tratamiento individual.



